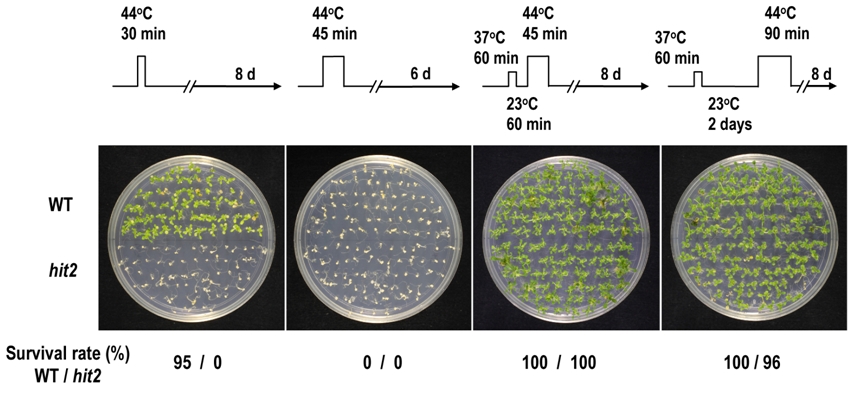

|
對抗因全球暖化所造成糧食減產的威脅
運用前向式遺傳學之策略研究植物耐熱機制
|
||
| 植物因為無法自由行動,故其生長會時刻受到環境的影響。而由於地球溫室效應的擴大,加之世界人口的增家,可耕地面積的減少,了解植物對抗高溫逆境的機制,進而找出提高農作物耐熱能力的途逕, 已成為世界各國必須且迫切需要面對的課題。而在諸多研究策略之中,又以找出植物負責抵抗高溫逆境的基因,以利遺傳工成之便,最受重視。
過去十年地表均溫變化的情形。紅色越深的區域,暖化現像越嚴重。
玉米適溫及高溫環境下生長的情形
要找出植物抵抗高溫逆境的遺傳因子,最通用的方法是經由基因體(genomics)或蛋白質體(proteomics)學,找出受高溫誘導表達的基因。利用這種方法,植物學家們已經獲得不少寶貴的資料,例如熱休克蛋白的基因表現及其在細胞分子生物學上的角色。然而,單是利用 基因體學及蛋白質體學的方式,並無法找出所有抵抗高溫逆境的基因。因為有許多基因的表現,雖不受高溫所誘導或抑制,但它們的產物卻是植物抵抗高溫逆境所不可或缺的。例如負責訊號感應,和訊號傳遞的基因。 很顯然的,必須有其它的研究策略,才能涵蓋現有的不足。因此,我們採用前向式遺傳學的方法 (forward genetics approach),來突破這個困境。當植物內部負責抵禦高溫逆境的基因,因突變而喪失功能,帶有此突變基因的植物,就會對高溫逆境失去耐受性(敏感型)。藉由對高溫逆境敏感型突變植 株的篩選,我們不但可以找出植物抵抗高溫逆境的遺傳因子,該遺傳因子的功能與角色,也可從對該突變植物的生理研究得到解答。 應用上述原理及方法,本實驗室已成功的從模式植物阿拉伯芥(Arabidopsis thaliana),篩選出若干對高溫逆境過度敏感的突變種植物。經由基因定位, 及後續的生理、細胞、遺傳、乃至於分子生物的實驗,至今我們已發現三個前所未知的植物耐熱基因(我們將它們命名為HIT1、HIT2及HIT4) ,並解構出它們保護植物免於高溫傷害的機制。在這之中:
=============================================
HIT1 HIT1為一囊泡繫鏈因子(Vesicle tethering factor)。囊泡繫鏈因子的細胞生理角色,主要是在調控生物分子(包括膜分子本身及膜上的蛋白質)在胞器間的轉運。 我們的研究發現,細胞在高溫逆境之下,HIT1可 以將葉綠體所生合成的飽合脂肪酸,運往細胞膜,藉此增加細胞膜的熱穩定性。而hit1突變 株失去該功能,是以其細胞膜會因熱而溶解,進而死亡。HIT1基因的發現,不僅是以前向式遺傳學研究植物耐熱機轉的代表作,更是第一個以實驗導出膜分子的轉運,對植物耐 受高溫逆境,有其不可或缺之角色的研究成果。(Wu et al., 2000, PDF; Lee et al., 2006, PDF; Wang et al, 2008, PDF; Wang et al., 2011, PDF)
|
||
|
|
||
|
W, 野生型;h, hit1 突變型; T, 將野生型HIT1 基因殖入hit1 突變型之轉殖株。幼苗在23oC萌發10天後移至37oC培育4天,照片攝於37oC培育前與培育後。
HIT1 藉囊泡運輸將葉綠體胞合脂質運往細胞膜以提高植物細胞耐熱力之示意圖。
|
||
|
=============================================
HIT2 HIT2是一種核膜運輸載體(nuclear transport receptor)。在真核細胞中,細胞核是由雙層膜所構成。大形生物分子通過細胞核膜,皆須 透過核膜運輸載體的辨識後,方能經由核孔(nuclear pore complex)進入或離開細胞核。HIT2保護植物免於高溫傷害的作用機轉,一部份是在於將熱逆境轉錄因子(Heat stress transcription factors, HSFs)適時移出細胞核。有趣的是,HIT2功能的喪失,只會降低植物的基礎耐熱能力(basal thermotolerance),而不會影響到植物的後天耐熱能力(acquired thermotolerance,見附圖) 。這個現像說明了,植物演化出不同的耐熱機轉,以面對不同型式的高溫逆境。而HIT2所調控的耐熱反應,主要是在保護植物遭遇直接且長時間的高溫逆境。hit2 突變株的篩選及HIT2的 功能分析,是第一個以實驗證明,植物演化出特殊核膜運輸載體,專門用來抵抗高溫逆境的研究。至於HIT2何以只影響植物的基礎耐熱能力,以及HIT2是否也調控植物抵抗其它非生物性的環境逆境(abiotice stress)的反應,這是我們刻正在研究的內容。(Wu et al., 2010, PDF)
HIT2功能的喪失,只會降低植物的基礎耐熱能力(basal thermotolerance),而不會影響到植物的後天耐熱能力(acquired thermotolerance)。
HIT2蛋白質(綠螢光GFP標定 )位於細胞核膜。紅螢光(RFP)標定處為細胞核。右邊兩小圖分別為綠、紅螢光重疊及可見光下的完整細胞。
=============================================
HIT4 HIT4是一 個從未被研究過的基因,其所編碼轉譯出的蛋白質,功能也是未知。是以我們要從一些最基本的實驗來逐步分析。經過一系列的研究後,我們發現HIT4蛋白質位於細胞核 內染色質中心(chromocenters)。 染色質中心是由異染色質絲(heterochromatin)集結而成的構造。眾所皆知,位於異染色質絲的基因,多半處於轉錄靜默(transcriptioanl gene silencing, TGS)的狀態。進一步的研究發現,植物在面臨高溫逆境時,染色質中心會消散開來,其內原先處於TGS狀態的基因則會被活化。而當HIT4因突變而喪失功能時,染色質中心不會因高溫環境而消散,而異染色質絲內的基因也回仍舊處於TGS狀態。這些實驗結果指出,HIT4是藉由改變染色質構形來誘導基因表現的調控因子。這是屬於表觀遺傳學(epigenetics)的一個領域。表觀遺傳學被視為是後基因體及後蛋白質體學最重要及發展前景的學門。而發現HIT4及證明其在植物耐熱反應中的必要角色,不但開創了一個全新的植物耐熱研究領域,也提供了生物學家一個探索表觀遺傳調控機轉的嶄新方向。目前我們正在對HIT4如何重塑染色質結構,就分子作用的層次做深入的研究中。(Wang et al., 2013, PDF)
HIT4蛋白質(綠螢光GFP標定 )位於細胞核內的染色質中心。紅螢光(RFP)標定處為細胞核。
野生型細胞核內之染色質中心,在受熱處理後會消散。hit4 突變株細胞核內之染色質中心,在若干加熱條件下,仍然維持緊密的結構。
|
||
|
=============================================
|
||
|
除了hit1 ,hit2 及 hit4 之外,本實驗室 還有許多熱敏感突變株未被研究。我們相信,每個突變株背後都有一個令人驚奇讚歎的道理。這部份正等待著有興趣及企圖心的新血,加入我們的團對,開創新局面。 |
||